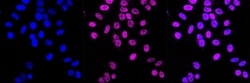
Invitrogen MCM3 Recombinant Rabbit Monoclonal Antibody (23GB2490), Invitrogen

missing translation for 'onlineSavingsMsg'
Learn More
Learn More
Invitrogen™ MCM3 Recombinant Rabbit Monoclonal Antibody (23GB2490), Invitrogen™
Rabbit Recombinant Monoclonal Antibody
Brand: Invitrogen™ MA553515
This item is not returnable.
View return policy
Description
The protein encoded by this gene is one of the highly conserved mini-chromosome maintenance proteins (MCM) that are involved in the initiation of eukaryotic genome replication. The hexameric protein complex formed by MCM proteins is a key component of the pre-replication complex (pre_RC) and may be involved in the formation of replication forks and in the recruitment of other DNA replication related proteins. This protein is a subunit of the protein complex that consists of MCM2-7. It has been shown to interact directly with MCM5/CDC46. This protein also interacts with, and thus is acetlyated by MCM3AP, a chromatin-associated acetyltransferase. The acetylation of this protein inhibits the initiation of DNA replication and cell cycle progression.
Specifications
| MCM3 | |
| Recombinant Monoclonal | |
| 0.4 mg/mL | |
| PBS with 50% glycerol and 0.02% sodium azide; pH 7.4 | |
| P25205, P25206 | |
| MCM3 | |
| A synthesized peptide derived from human HLTF (1-44AA). | |
| 20 μL | |
| Primary | |
| Human, Mouse, Rat | |
| Antibody | |
| IgG |
| Flow Cytometry, Western Blot, Immunocytochemistry | |
| 23GB2490 | |
| Unconjugated | |
| MCM3 | |
| AL033361; C80350; cervical cancer proto-oncogene 5; DNA polymerase alpha holoenzyme-associated protein P1; DNA replication factor MCM3; DNA replication licensing factor MCM3; HCC5; hRlf beta subunit; MCM3; MCM3 minichromosome maintenance deficient 3; Mcmd; Mcmd3; MGC1157; mini chromosome maintenance deficient; minichromosome maintenance complex component 3; minichromosome maintenance deficient 3; minichromosome maintenance deficient 3 (S. cerevisiae); P1; P1.h; p1.m; p102; P1-MCM3; replication licensing factor, beta subunit; RLF subunit beta; RLFB; RP1-108C2.3 | |
| Rabbit | |
| Affinity chromatography | |
| RUO | |
| 17215, 316273, 4172 | |
| -20°C | |
| Liquid |
Product Content Correction
Your input is important to us. Please complete this form to provide feedback related to the content on this product.
Product Title
Spot an opportunity for improvement?Share a Content Correction